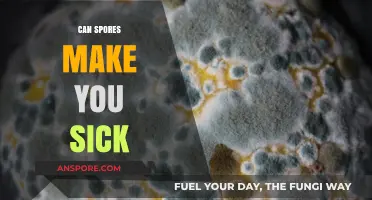
Can Spores Make You Sick? Understanding Health Risks and Prevention

Spores, the resilient reproductive units of certain plants, fungi, and bacteria, possess an extraordinary ability to endure extreme conditions, including the passage of time. One of the most fascinating aspects of spores is their capacity to remain dormant for hundreds, and even thousands, of years, a phenomenon often referred to as cryptobiosis. During this state of suspended animation, spores can withstand harsh environments, such as extreme temperatures, desiccation, and radiation, by slowing down their metabolic processes to an almost imperceptible rate. This remarkable adaptability allows spores to persist in soil, water, and other substrates, waiting for optimal conditions to germinate and resume growth. The discovery of viable spores in ancient sediments, amber, and even permafrost has provided compelling evidence that spores can indeed rest for centuries, challenging our understanding of the limits of life and its ability to survive in the most inhospitable environments.
| Characteristics | Values |
|---|---|
| Viability | Spores can remain viable for hundreds to thousands of years under favorable conditions, such as low temperature, low oxygen, and low moisture. |
| Examples | Bacterial spores (e.g., Bacillus species) and fungal spores (e.g., Aspergillus species) have been revived after being dormant for centuries. |
| Mechanism | Spores enter a state of metabolic dormancy, reducing their need for nutrients and energy, which allows them to survive extreme conditions. |
| Environment | Spores can survive in harsh environments, including permafrost, deep-sea sediments, and arid deserts, where they are protected from degradation. |
| Revival | When exposed to favorable conditions (e.g., water, nutrients, and suitable temperature), spores can germinate and resume metabolic activity. |
| Significance | The ability of spores to remain dormant for extended periods has implications for biotechnology, astrobiology, and the study of ancient ecosystems. |
| Record | The oldest revived spores are estimated to be around 250 million years old, found in salt crystals and halite deposits. |
| Applications | Spores' longevity is utilized in food preservation, probiotics, and the development of long-term storage solutions for microorganisms. |
Explore related products
$25.54 $28.01
What You'll Learn
- Survival Mechanisms: How spores withstand extreme conditions like heat, cold, and radiation for centuries
- Dormancy Triggers: Environmental factors that induce spore dormancy and extend their lifespan
- Revival Conditions: Specific conditions required to awaken dormant spores after long periods
- Historical Examples: Documented cases of spores germinating after hundreds of years
- Ecological Impact: Role of long-resting spores in ecosystems and biodiversity preservation

Survival Mechanisms: How spores withstand extreme conditions like heat, cold, and radiation for centuries
Spores, the resilient reproductive units of certain bacteria, fungi, and plants, can endure conditions that would annihilate most life forms. Their ability to remain dormant for centuries, surviving extreme heat, cold, and radiation, hinges on a suite of ingenious survival mechanisms. One key strategy is their desiccation tolerance. By shedding nearly all internal water, spores enter a state of suspended animation, halting metabolic processes that would otherwise degrade their cellular structures. This near-complete dehydration acts as a molecular pause button, allowing them to withstand temperatures ranging from the cryogenic depths of -80°C to the scorching heat of 150°C. For context, such extremes would denature proteins and rupture cell membranes in most organisms, yet spores emerge unscathed.
Another critical survival mechanism is the robust spore coat, a multilayered shield composed of proteins, peptides, and polymers. This coat acts as a barrier against radiation, including UV light and ionizing radiation, which can fragment DNA and disrupt cellular function. For instance, bacterial endospores, such as those of *Bacillus subtilis*, possess a coat that absorbs and scatters radiation, reducing its penetration into the spore’s core. Studies show that spores can survive doses of radiation exceeding 10,000 Grays—enough to kill a human instantly. This protective layer also prevents the entry of desiccating agents and toxic chemicals, further safeguarding the spore’s genetic material.
The metabolic shutdown of spores is equally remarkable. By halting all energy-consuming processes, spores minimize the accumulation of reactive oxygen species (ROS), which are byproducts of metabolism that can damage DNA, proteins, and lipids. In this dormant state, spores maintain their integrity for centuries, waiting for favorable conditions to resume growth. For example, spores of the fungus *Talaromyces* have been revived from 40-million-year-old amber, demonstrating their unparalleled longevity. This metabolic quiescence is not merely a passive state but an actively maintained condition, regulated by specific genes and proteins that ensure the spore’s survival.
Practical applications of spore resilience abound. In the food industry, understanding spore survival helps develop sterilization techniques like autoclaving, which uses steam at 121°C and 15 psi for 15 minutes to kill even the hardiest spores. In space exploration, spores serve as model organisms for studying life’s potential to endure extraterrestrial conditions. For instance, experiments on the International Space Station exposed spores to the vacuum of space, extreme temperatures, and cosmic radiation, revealing their capacity to survive for years outside Earth’s protective atmosphere. This knowledge informs astrobiology and the search for life beyond our planet.
To harness spore resilience in everyday life, consider their role in probiotics and soil health. Certain spore-forming bacteria, like *Bacillus coagulans*, survive the acidic environment of the stomach to deliver beneficial effects in the gut. Gardeners can capitalize on spore longevity by using biofertilizers containing dormant spores, which activate when soil conditions are optimal. However, caution is warranted: spore survival also poses challenges, such as food spoilage and antibiotic resistance. Understanding these mechanisms not only deepens our appreciation for life’s tenacity but also equips us to combat threats and leverage spores’ potential in biotechnology and beyond.
Are Spores Multicellular or Unicellular? Unraveling the Mystery
You may want to see also

Dormancy Triggers: Environmental factors that induce spore dormancy and extend their lifespan
Spores, the resilient reproductive units of fungi, algae, and certain plants, possess an extraordinary ability to enter a state of dormancy, allowing them to withstand harsh environmental conditions for extended periods. This phenomenon raises the question: what triggers this dormancy, and how can it be prolonged? Understanding the environmental factors that induce spore dormancy is crucial for various fields, from agriculture to astrobiology.
The Role of Desiccation and Nutrient Deprivation
One of the most potent triggers of spore dormancy is desiccation, or extreme dryness. When spores are exposed to low humidity levels, they enter a quiescent state to conserve energy and protect their cellular structures. For example, *Selaginella lepidophylla*, a desert plant, produces spores that can remain dormant for decades in arid conditions, reviving only when moisture returns. Similarly, nutrient deprivation plays a critical role. Spores of fungi like *Aspergillus* and *Penicillium* enter dormancy when essential nutrients such as nitrogen or carbon are scarce. Laboratory studies show that reducing nutrient availability by 90% can extend spore lifespan by up to 50%. To replicate this effect, researchers often use controlled environments with nutrient-poor media to study dormancy mechanisms.
Temperature Extremes and Light Exposure
Temperature fluctuations act as another significant dormancy trigger. Spores of organisms like *Bacillus subtilis* can survive freezing temperatures or extreme heat by entering a dormant state. For instance, spores exposed to -20°C or 80°C show increased longevity compared to those kept at room temperature. Light exposure, particularly ultraviolet (UV) radiation, also influences dormancy. UV-B rays can damage spore DNA, prompting them to enter a protective dormant phase. However, prolonged exposure can be detrimental, so spores often balance dormancy with repair mechanisms. Practical applications include using UV-shielding materials in spore storage to extend viability while minimizing damage.
Chemical Signals and pH Levels
Chemical cues in the environment can induce or inhibit spore dormancy. For example, high salt concentrations, as found in saline soils, trigger dormancy in halophyte plant spores. Similarly, pH levels play a critical role; spores of acidophilic fungi thrive in low-pH environments but enter dormancy in neutral or alkaline conditions. A study on *Neurospora crassa* spores found that a pH shift from 5 to 7 reduced germination rates by 80%. To manipulate dormancy, researchers adjust pH levels in growth media, providing insights into spore resilience in varying ecosystems.
Practical Applications and Future Directions
Understanding dormancy triggers has practical implications for food preservation, biotechnology, and space exploration. For instance, controlling humidity, temperature, and nutrient levels can extend the shelf life of spore-based products like probiotics or agricultural inoculants. In astrobiology, studying spore dormancy helps assess the potential for life to survive on other planets. For enthusiasts or researchers, simple experiments like exposing spores to controlled desiccation or temperature extremes can demonstrate dormancy mechanisms firsthand. By harnessing these environmental factors, we can unlock the full potential of spores’ remarkable longevity.
Can Spore Run on Windows 8 via Steam? Compatibility Guide
You may want to see also

Revival Conditions: Specific conditions required to awaken dormant spores after long periods
Spores, the resilient survival structures of certain bacteria, fungi, and plants, can indeed remain dormant for hundreds of years, waiting for the precise conditions to reawaken. This remarkable ability hinges on a delicate interplay of environmental factors that signal safety and opportunity for growth. Understanding these revival conditions is crucial for fields ranging from microbiology to agriculture and even space exploration.
While spores are famously tough, their awakening isn't a random event. Specific triggers are required to coax them out of dormancy. These conditions act as a biological green light, signaling that the environment is conducive to growth and reproduction.
The Recipe for Revival: Key Ingredients
- Moisture: Water is essential for spore germination. A relative humidity above 90% is often necessary, though some spores require specific moisture levels. For example, certain fungal spores may need a brief period of high moisture followed by a drier phase to trigger germination.
- Temperature: Optimal temperatures vary widely depending on the spore species. Some thrive in the warmth of tropical climates (25-30°C), while others prefer cooler environments (10-15°C). Extreme temperatures, both hot and cold, can damage or kill spores.
- Nutrient Availability: While spores themselves are metabolically inactive, they require nutrients to fuel the initial stages of germination. Simple sugars, amino acids, and other organic compounds often serve as the necessary fuel source.
- Light: Light, particularly specific wavelengths, can act as a powerful trigger for some spores. For instance, certain plant spores require exposure to red light to break dormancy.
Beyond the Basics: Fine-Tuning the Environment
The revival process is often more nuanced than simply providing the basic necessities. Some spores require specific pH levels, oxygen concentrations, or even the presence of certain chemicals to initiate germination. For example, some bacterial spores require exposure to specific enzymes or antibiotics to weaken their protective coats before they can germinate.
Additionally, the age of the spore can influence its revival requirements. Older spores may have accumulated damage and require more favorable conditions or specific repair mechanisms to successfully germinate.
Practical Applications: Harnessing the Power of Dormancy
Understanding revival conditions has practical implications in various fields. In agriculture, knowing how to awaken beneficial soil microbes can enhance crop yields and soil health. In food preservation, controlling these conditions can prevent spoilage caused by dormant spores. Furthermore, studying spore revival mechanisms can inform strategies for long-term space travel, where understanding how to preserve and reactivate life forms in extreme conditions is crucial.
By deciphering the intricate code of spore revival, we gain valuable insights into the remarkable resilience of life and unlock new possibilities for harnessing its potential.
Are Spores Always Male? Unraveling the Gender Mystery in Fungi
You may want to see also
Explore related products

Historical Examples: Documented cases of spores germinating after hundreds of years
Spores, the resilient reproductive units of certain plants, algae, and fungi, have long fascinated scientists with their ability to endure extreme conditions. Historical records and scientific studies provide compelling evidence that spores can indeed remain dormant for centuries, only to germinate when conditions become favorable. One of the most striking examples comes from the Antarctic, where researchers discovered viable fungal spores trapped in ice cores estimated to be over 1,000 years old. Upon thawing, these spores successfully germinated, demonstrating their extraordinary longevity. This finding not only highlights the survival capabilities of spores but also raises questions about their potential role in ecosystem recovery after prolonged dormancy.
Another notable case involves the resurrection of plants from ancient spores found in sedimentary deposits. In Japan, scientists unearthed spores of a fern species, *Osmunda regalis*, from a layer of soil dated to the early Holocene, approximately 700 years ago. When exposed to water and light, these spores sprouted, producing healthy fern plants. This experiment underscores the importance of environmental cues in triggering germination and suggests that spores can act as biological time capsules, preserving genetic material across centuries. Such discoveries have practical implications for conservation efforts, as they indicate that dormant spores could contribute to the restoration of extinct or endangered plant species.
Historical archives also document instances of spores surviving in man-made environments. For example, during the restoration of an 18th-century herbarium in Europe, botanists noticed mold growth on dried plant specimens. Analysis revealed that the mold originated from fungal spores embedded in the paper, which had remained dormant for over 200 years. This accidental germination highlights the spores' ability to withstand desiccation and chemical exposure, conditions typically found in archival settings. It also serves as a cautionary tale for archivists, emphasizing the need for climate-controlled storage to prevent unintended biological activity.
Comparatively, the germination of ancient spores found in permafrost offers insights into their role in climate change research. In Siberia, scientists extracted spores from frozen soil layers dating back 400 years and successfully cultivated them in laboratory conditions. These spores, belonging to various fungal species, exhibited remarkable adaptability, thriving despite centuries of subzero temperatures. This resilience suggests that as global warming thaws permafrost, dormant spores could re-emerge, potentially altering microbial communities and nutrient cycles in Arctic ecosystems. Such findings underscore the need for long-term ecological monitoring to predict the impact of these "zombie spores" on fragile environments.
Practical applications of these historical examples extend beyond scientific curiosity. For instance, the agricultural sector could benefit from understanding how spores survive extreme conditions, potentially leading to the development of hardier crop varieties. Additionally, the study of ancient spores provides a unique window into past ecosystems, allowing researchers to reconstruct historical biodiversity and track environmental changes over time. By preserving and studying these microscopic time capsules, we not only unravel the mysteries of spore dormancy but also harness their potential for addressing contemporary challenges in conservation, agriculture, and climate science.
Exploring Fungal Reproduction: Can Spores Be Produced Sexually?
You may want to see also

Ecological Impact: Role of long-resting spores in ecosystems and biodiversity preservation
Spores, the resilient reproductive units of fungi, algae, and certain plants, possess an extraordinary ability to endure dormancy for centuries, even millennia. This phenomenon, known as long-term spore dormancy, plays a pivotal role in shaping ecosystems and preserving biodiversity. Imagine a time capsule, not of human artifacts, but of microscopic life, waiting patiently for the right conditions to awaken and contribute to the vibrant tapestry of life.
These dormant spores act as a genetic reservoir, safeguarding species through environmental upheavals like wildfires, droughts, or glacial periods. When conditions become favorable, they germinate, reintroducing species that might have otherwise been lost, ensuring ecological resilience and stability.
Consider the aftermath of a forest fire. The scorched earth, seemingly devoid of life, holds a secret: a bank of dormant spores embedded in the soil. As rain nourishes the ashes and sunlight penetrates the canopy, these spores spring to life, giving rise to new fungi that decompose fallen trees, enriching the soil, and paving the way for the return of plant life. This process, known as ecological succession, relies heavily on the presence of these long-resting spores, demonstrating their crucial role in ecosystem recovery.
Studies have shown that certain fungal spores can remain viable for over 10,000 years in permafrost, highlighting their remarkable longevity. This extended dormancy allows them to bridge temporal gaps, connecting past ecosystems with the present and potentially even the future.
The preservation of biodiversity hinges on the ability of ecosystems to adapt and recover from disturbances. Long-resting spores contribute to this adaptability by providing a genetic pool that can respond to changing environmental conditions. For instance, as climate change alters temperature and precipitation patterns, dormant spores of species better suited to the new conditions may germinate, ensuring the continued functioning of the ecosystem.
Understanding the ecological significance of long-resting spores has practical implications for conservation efforts. Preserving habitats that harbor these dormant spores, such as undisturbed soils and ancient forests, becomes crucial for maintaining biodiversity. Additionally, incorporating knowledge of spore dormancy into restoration projects can enhance their success by reintroducing species that have been locally extinct for centuries.
In essence, long-resting spores are not merely passive bystanders in the ecological drama; they are active participants, ensuring the continuity of life and the resilience of ecosystems in the face of change. Their ability to endure through time underscores the intricate web of life and highlights the importance of preserving the unseen, microscopic world that underpins our planet's biodiversity.
Best Places to Purchase Morel Mushroom Spores for Cultivation
You may want to see also
Frequently asked questions
Yes, many types of spores, such as those from bacteria, fungi, and plants, can remain dormant for hundreds or even thousands of years under the right conditions.
Spores can survive for extended periods in environments with low oxygen, low moisture, and stable temperatures, such as in soil, permafrost, or sealed containers.
No, the longevity of spores varies by species. For example, bacterial endospores and certain fungal spores are known for their exceptional ability to endure harsh conditions for centuries.
Yes, if the spores are viable and encounter favorable conditions, they can germinate and grow into new organisms even after centuries of dormancy.
Yes, scientists have successfully revived spores from sources like ancient permafrost, amber, and herbarium specimens, some of which were hundreds or thousands of years old.